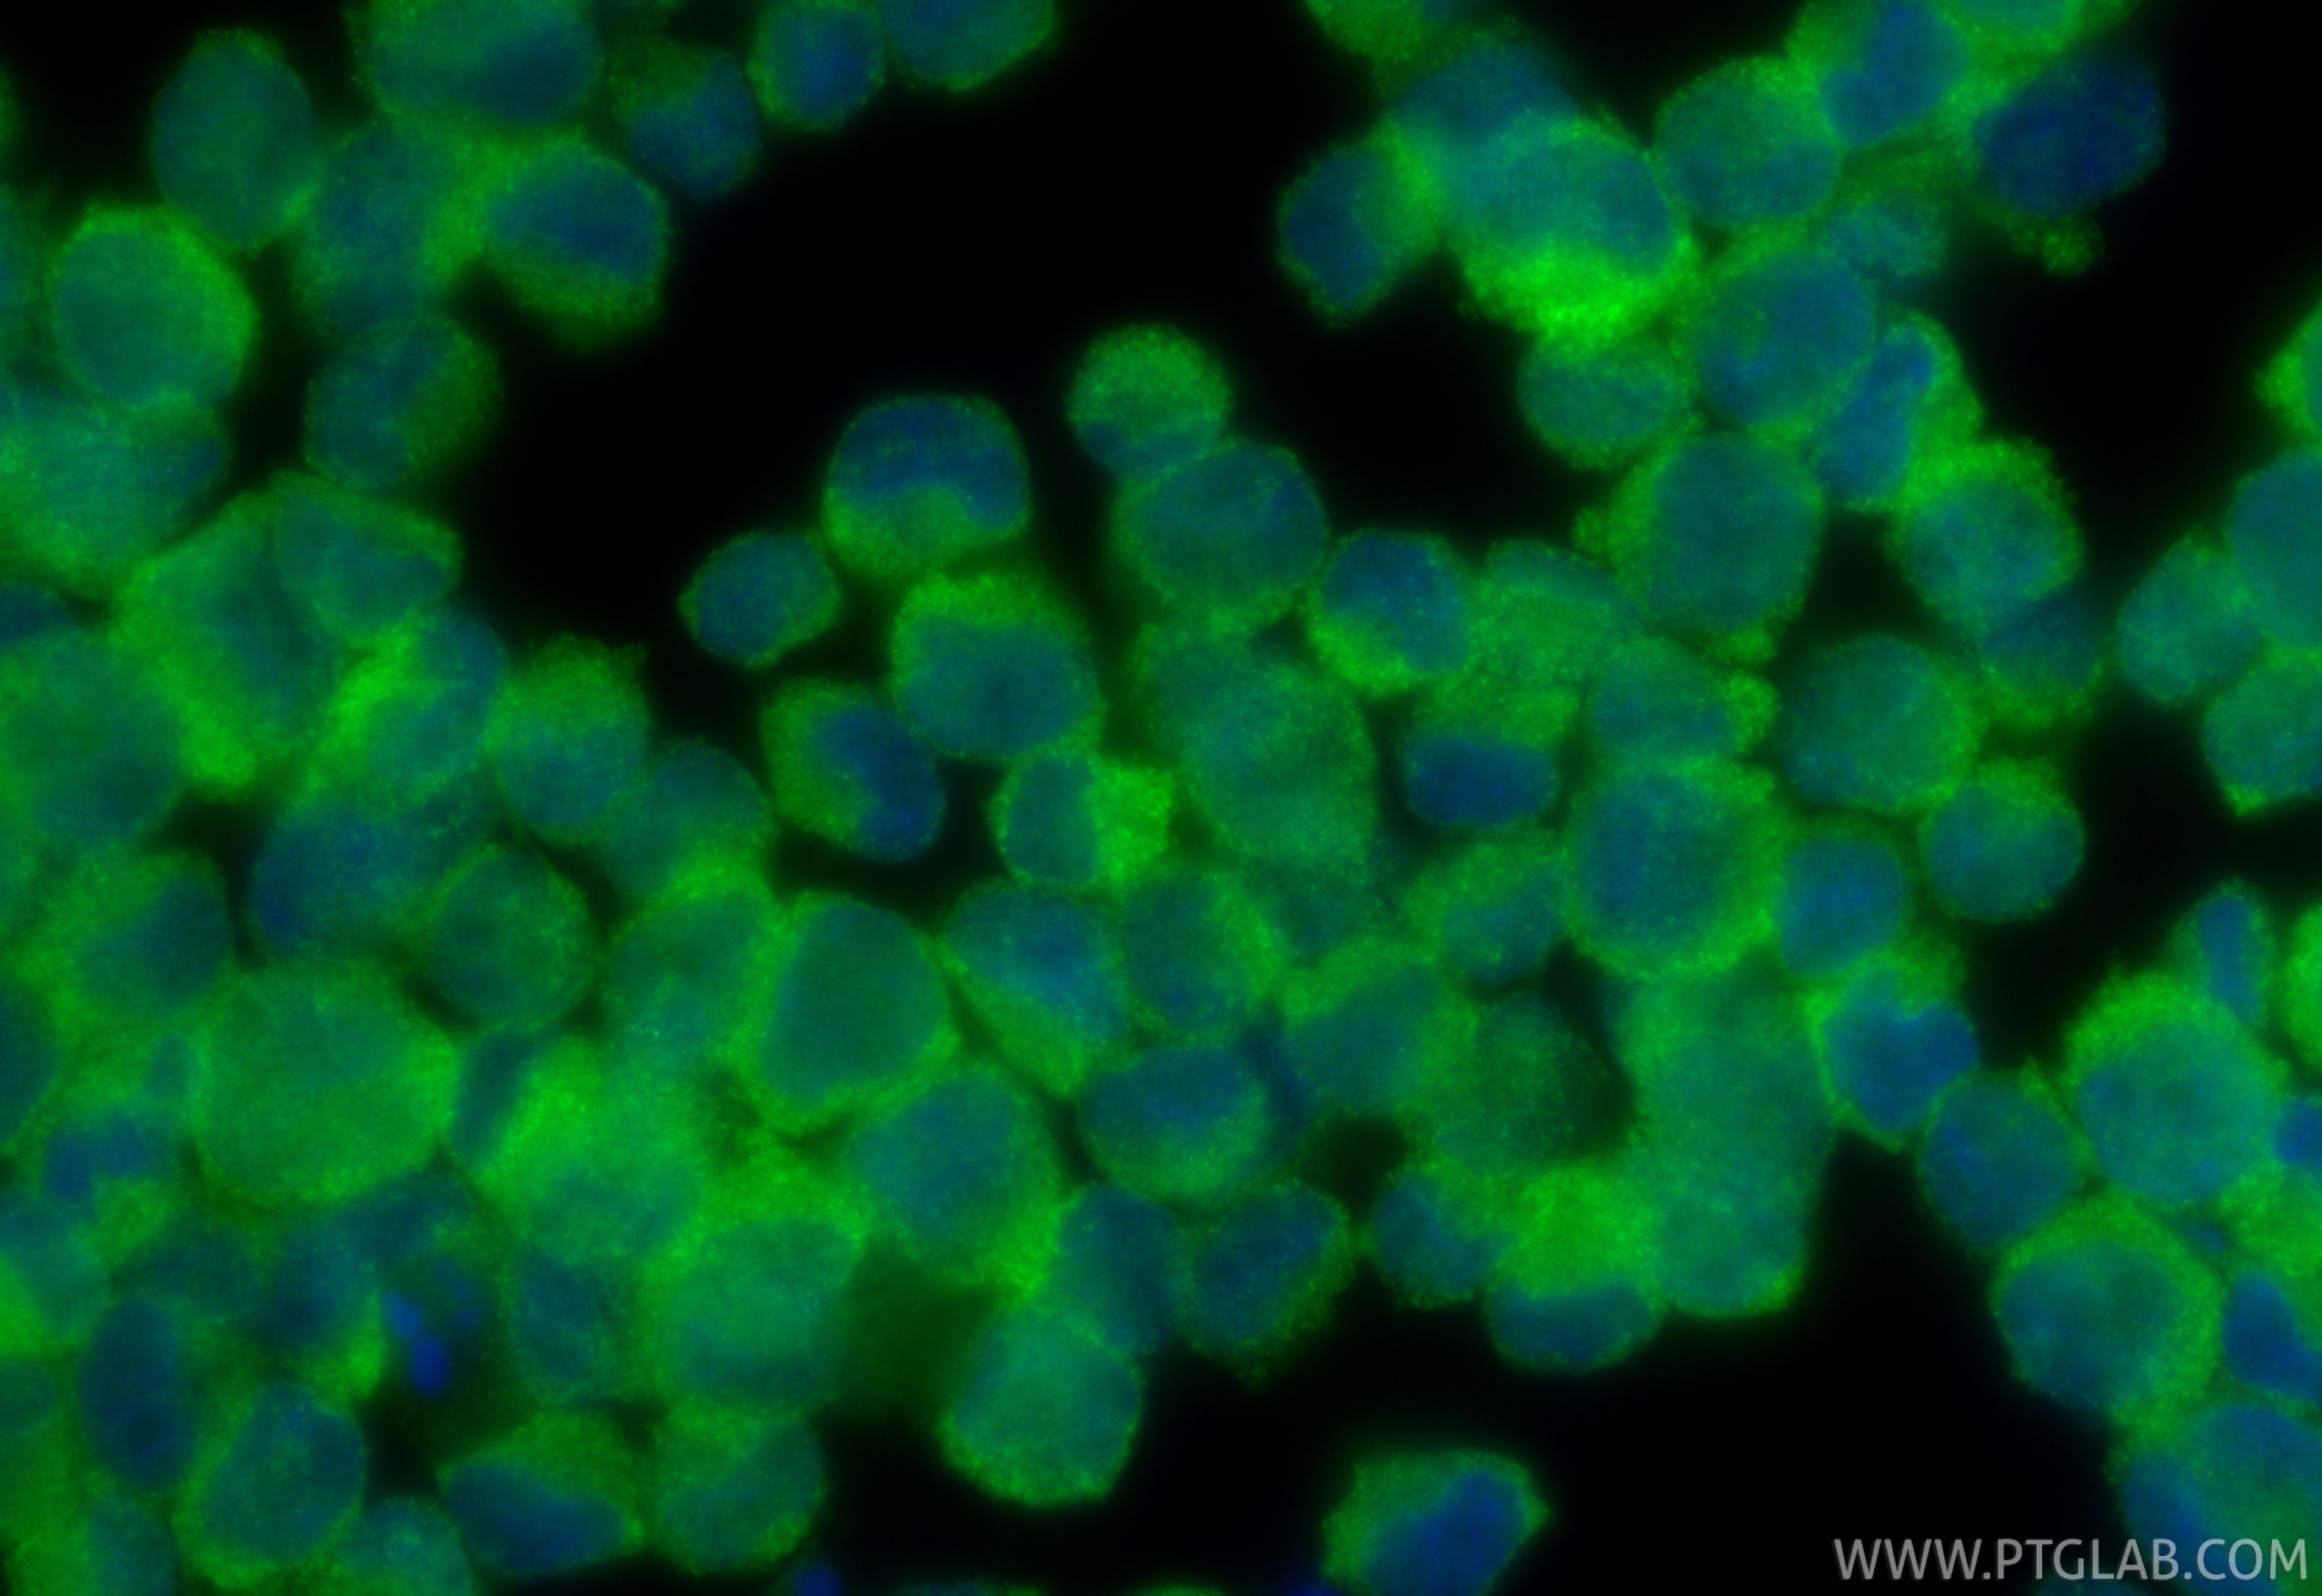
Immunofluorescence (IF) / fluorescent staining of K-562 cells using TFE3 Polyclonal antibody (14480-1-AP)

Tested Applications
| Positive WB detected in | K-562 cells, human brain tissue, mouse spleen tissue, rat brain tissue |
| Positive IP detected in | K-562 cells |
| Positive IHC detected in | human renal cell carcinoma tissue Note: suggested antigen retrieval with TE buffer pH 9.0; (*) Alternatively, antigen retrieval may be performed with citrate buffer pH 6.0 |
| Positive IF/ICC detected in | K-562 cells |
Recommended dilution
| Application | Dilution |
|---|---|
| Western Blot (WB) | WB : 1:500-1:2000 |
| Immunoprecipitation (IP) | IP : 0.5-4.0 ug for 1.0-3.0 mg of total protein lysate |
| Immunohistochemistry (IHC) | IHC : 1:50-1:500 |
| Immunofluorescence (IF)/ICC | IF/ICC : 1:50-1:500 |
| It is recommended that this reagent should be titrated in each testing system to obtain optimal results. | |
| Sample-dependent, Check data in validation data gallery. | |
Published Applications
| KD/KO | See 4 publications below |
| WB | See 18 publications below |
| IF | See 10 publications below |
| IP | See 2 publications below |
| CoIP | See 1 publications below |
| ChIP | See 5 publications below |
Product Information
14480-1-AP targets TFE3 in WB, IHC, IF/ICC, IP, CoIP, ChIP, ELISA applications and shows reactivity with human, mouse, rat samples.
| Tested Reactivity | human, mouse, rat |
| Cited Reactivity | human, mouse, rat |
| Host / Isotype | Rabbit / IgG |
| Class | Polyclonal |
| Type | Antibody |
| Immunogen |
CatNo: Ag5863 Product name: Recombinant human TFE3 protein Source: e coli.-derived, PGEX-4T Tag: GST Domain: 1-350 aa of BC026027 Sequence: MSHAAEPARDGVEASAEGPRAVFVLLEERRPADSAQLLSLNSLLPESGIVADIELENVLDPDSFYELKSQPLPLRSSLPISLQATPATPATLSASSSAGGSRTPAMSSSSSSRVLLRQQLMRAQAQEQERRERREQAAAAPFPSPAPASPAISVVGVSAGGHTLSRPPPAQVPREVLKVQTHLENPTRYHLQQARRQQVKQYLSTTLGPKLASQALTPPPGPASAQPLPAPEAAHTTGPTGSAPNSPMALLTIGSSSEKEIDDVIDEIISLESSYNDEMLSYLPGGTTGLQLPSTLPVSGNLLDVYSSQGVATPAITVSNSCPAELPNIKREISETEAKALLKERQKKDN Predict reactive species |
| Full Name | transcription factor binding to IGHM enhancer 3 |
| Calculated Molecular Weight | 62 kDa |
| Observed Molecular Weight | 70 kDa |
| GenBank Accession Number | BC026027 |
| Gene Symbol | TFE3 |
| Gene ID (NCBI) | 7030 |
| RRID | AB_2199587 |
| Conjugate | Unconjugated |
| Form | Liquid |
| Purification Method | Antigen affinity purification |
| UNIPROT ID | P19532 |
| Storage Buffer | PBS with 0.02% sodium azide and 50% glycerol, pH 7.3. |
| Storage Conditions | Store at -20°C. Stable for one year after shipment. Aliquoting is unnecessary for -20oC storage. 20ul sizes contain 0.1% BSA. |
Background Information
The protein encoded by this gene is a subunit of the CRSP (cofactor required for SP1 activation) complex, which, along with TFIID, is required for efficient activation by SP1. This protein is also a component of other multisubunit complexes e.g. thyroid hormone receptor-(TR-) associated proteins which interact with TR and facilitate TR function on DNA templates in conjunction with initiation factors and cofactors.
Protocols
| Product Specific Protocols | |
|---|---|
| IF protocol for TFE3 antibody 14480-1-AP | Download protocol |
| IHC protocol for TFE3 antibody 14480-1-AP | Download protocol |
| IP protocol for TFE3 antibody 14480-1-AP | Download protocol |
| WB protocol for TFE3 antibody 14480-1-AP | Download protocol |
| Standard Protocols | |
|---|---|
| Click here to view our Standard Protocols |
Publications
| Species | Application | Title |
|---|---|---|
Cell Death Differ Lysine methylation of PPP1CA by the methyltransferase SUV39H2 disrupts TFEB-dependent autophagy and promotes intervertebral disc degeneration | ||
Autophagy Oxidation of multiple MiT/TFE transcription factors links oxidative stress to transcriptional control of autophagy and lysosome biogenesis. | ||
Autophagy PRCC-TFE3 fusion-mediated PRKN/parkin-dependent mitophagy promotes cell survival and proliferation in PRCC-TFE3 translocation renal cell carcinoma.
| ||
Cell Discov Targeting macrophage TFEB-14-3-3 epsilon Interface by naringenin inhibits abdominal aortic aneurysm. | ||
J Biol Chem TFE3-SLC36A1 axis promotes resistance to glucose starvation in kidney cancer cells | ||
Bioorg Med Chem Terpenoids isolated from Chinese liverworts Lepidozia reptans and their anti-inflammatory activity. |